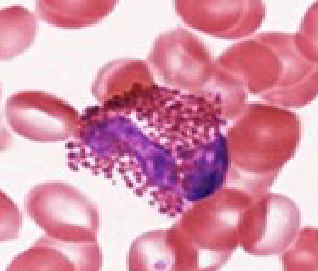
term image

1/27
Mastrangelo lab 1 (sem 2)
Name | Mastery | Learn | Test | Matching | Spaced | Call with Kai |
|---|
No analytics yet
Send a link to your students to track their progress
What percentage of blood volume is plasma?
55%
What is plasma composed of?
Water, electrolytes, proteins, hormones, antibodies and nutrients
What is the normal range for RBCs?
4-6 million/ uL
Lifespan of RBCs?
120 days
Normal Hemoglobin range (men)?
14-18 gm/100 mL
Normal Hemoglobin range (women)?
12-16 gm / 100 mL
Large bone marrow cell with lobed nucleus; responsible for platelet production?
Megakaryocyte
Thrombocytes - second most numerous circulating cell in the body?
Platelets
ADP, ATP, seratonin, glutamate, Ca2+, polyphosphate and epineprine?
Dense Granules
Fibrinogen, Fibroconnectin, Thrombospondin, vWF, PDGF, TGF-b, TGF-a, ECCGF, GGF and P-selectin?
Alpha Granules
Steps for platelet activation?
Shape change, granule release, aggregation, adhesion molecule expression
Normal WBC range?
4,500 - 11,000 / uL
Phagocytes with cytoplasmic granules and lobed nuclei?
Granulocytes
No granules and spherical / kidney - shaped nuclei?
Agranulocytes

Neutrophil (55-70%)
Eosinophil (1-4%)

Basophil (0.5-1%)

Lymphocyte (20-40%)

Monocyte (2-8%)
Epithelial cells, monocytes, macrophages, dendritic cells, neutrophils, eosinophils, basophils and mast cells?
Innate Immunity
Th1 cells, Th2, Th17, Th9, Th22, T reg cells, Cytotoxic T cells and B cells?
Adaptive Immunity
NK cells, NKT cells, T cells, Lymphoid cells?
Both Innate and adaptive
What occurs when antigen is mixed with its corresponding antibody?
Agglutination
Condition where body does not get enough oxygen (blood lacks red cells / hemoglobin)?
Anemia
Rare genetic disorder where blood does not clot?
Hemophilia
Alteration in genes affecting VWF
Von Willebrand Disease
How / where are RBCs recycled?
By macrophages in the spleen
OG blood stem cell (precursor to both myeloid and lymphoid progenitors)
Hemocytoblast